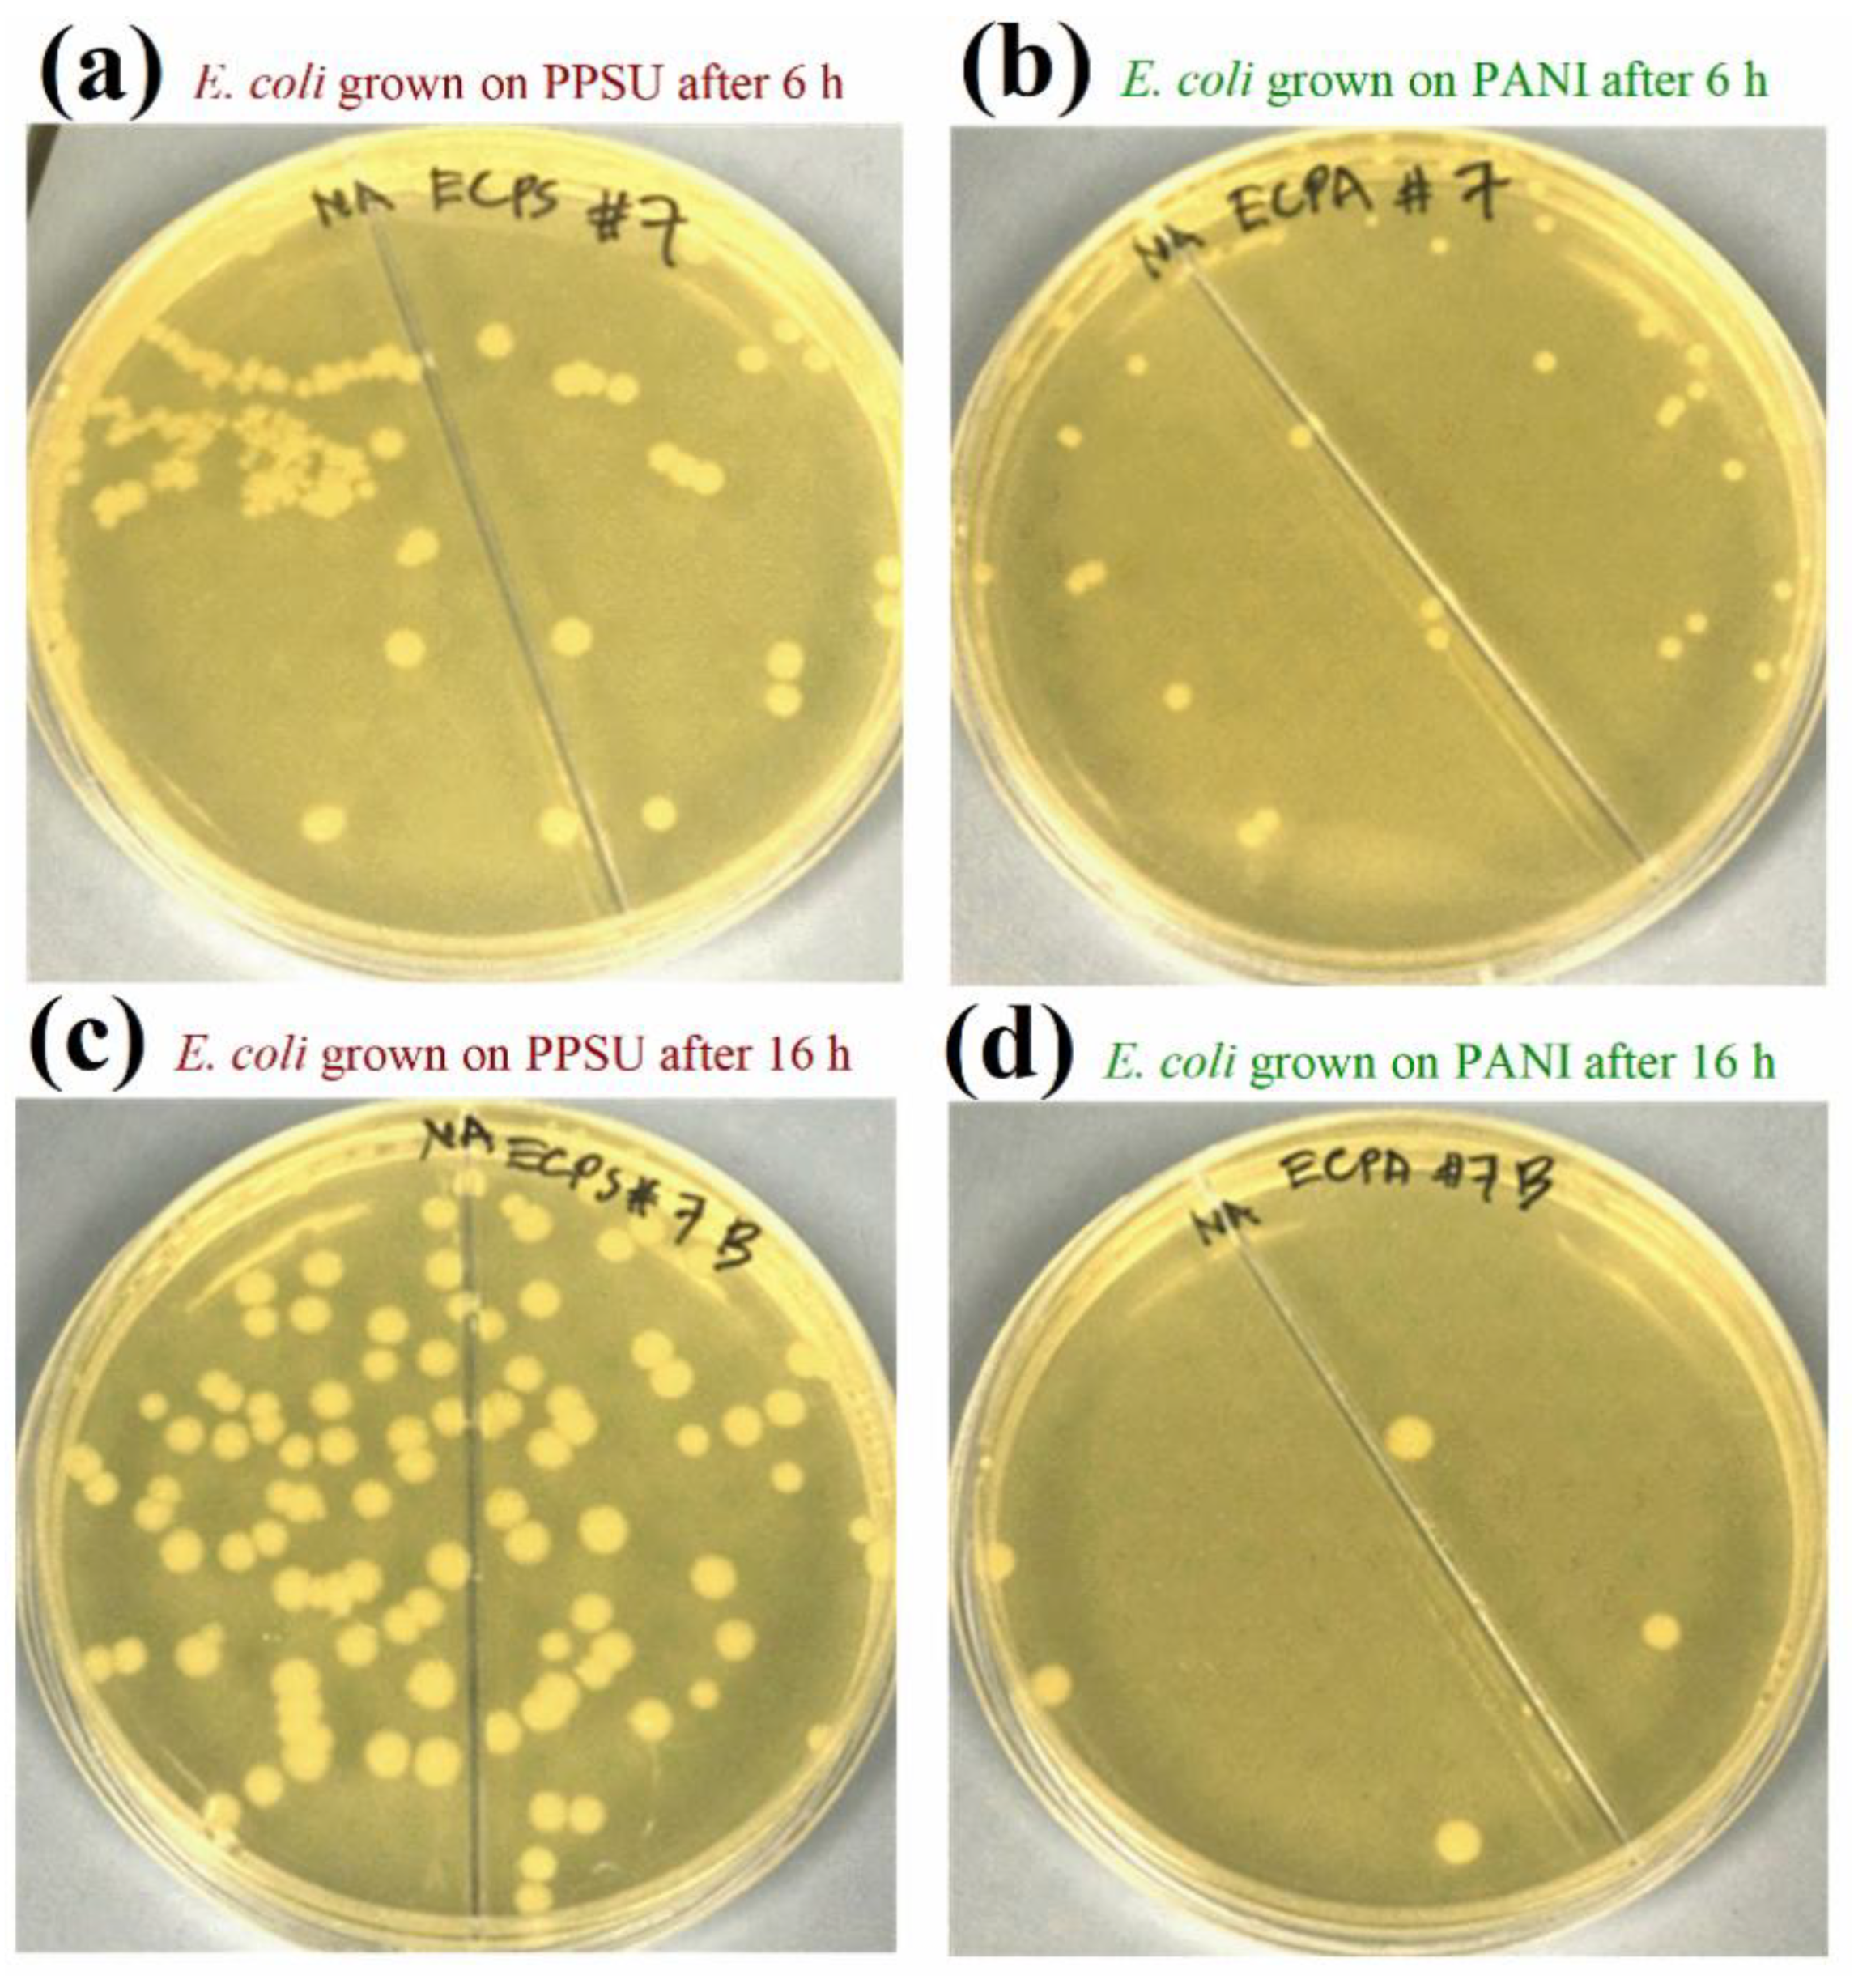
Membranes 11 00025 g009
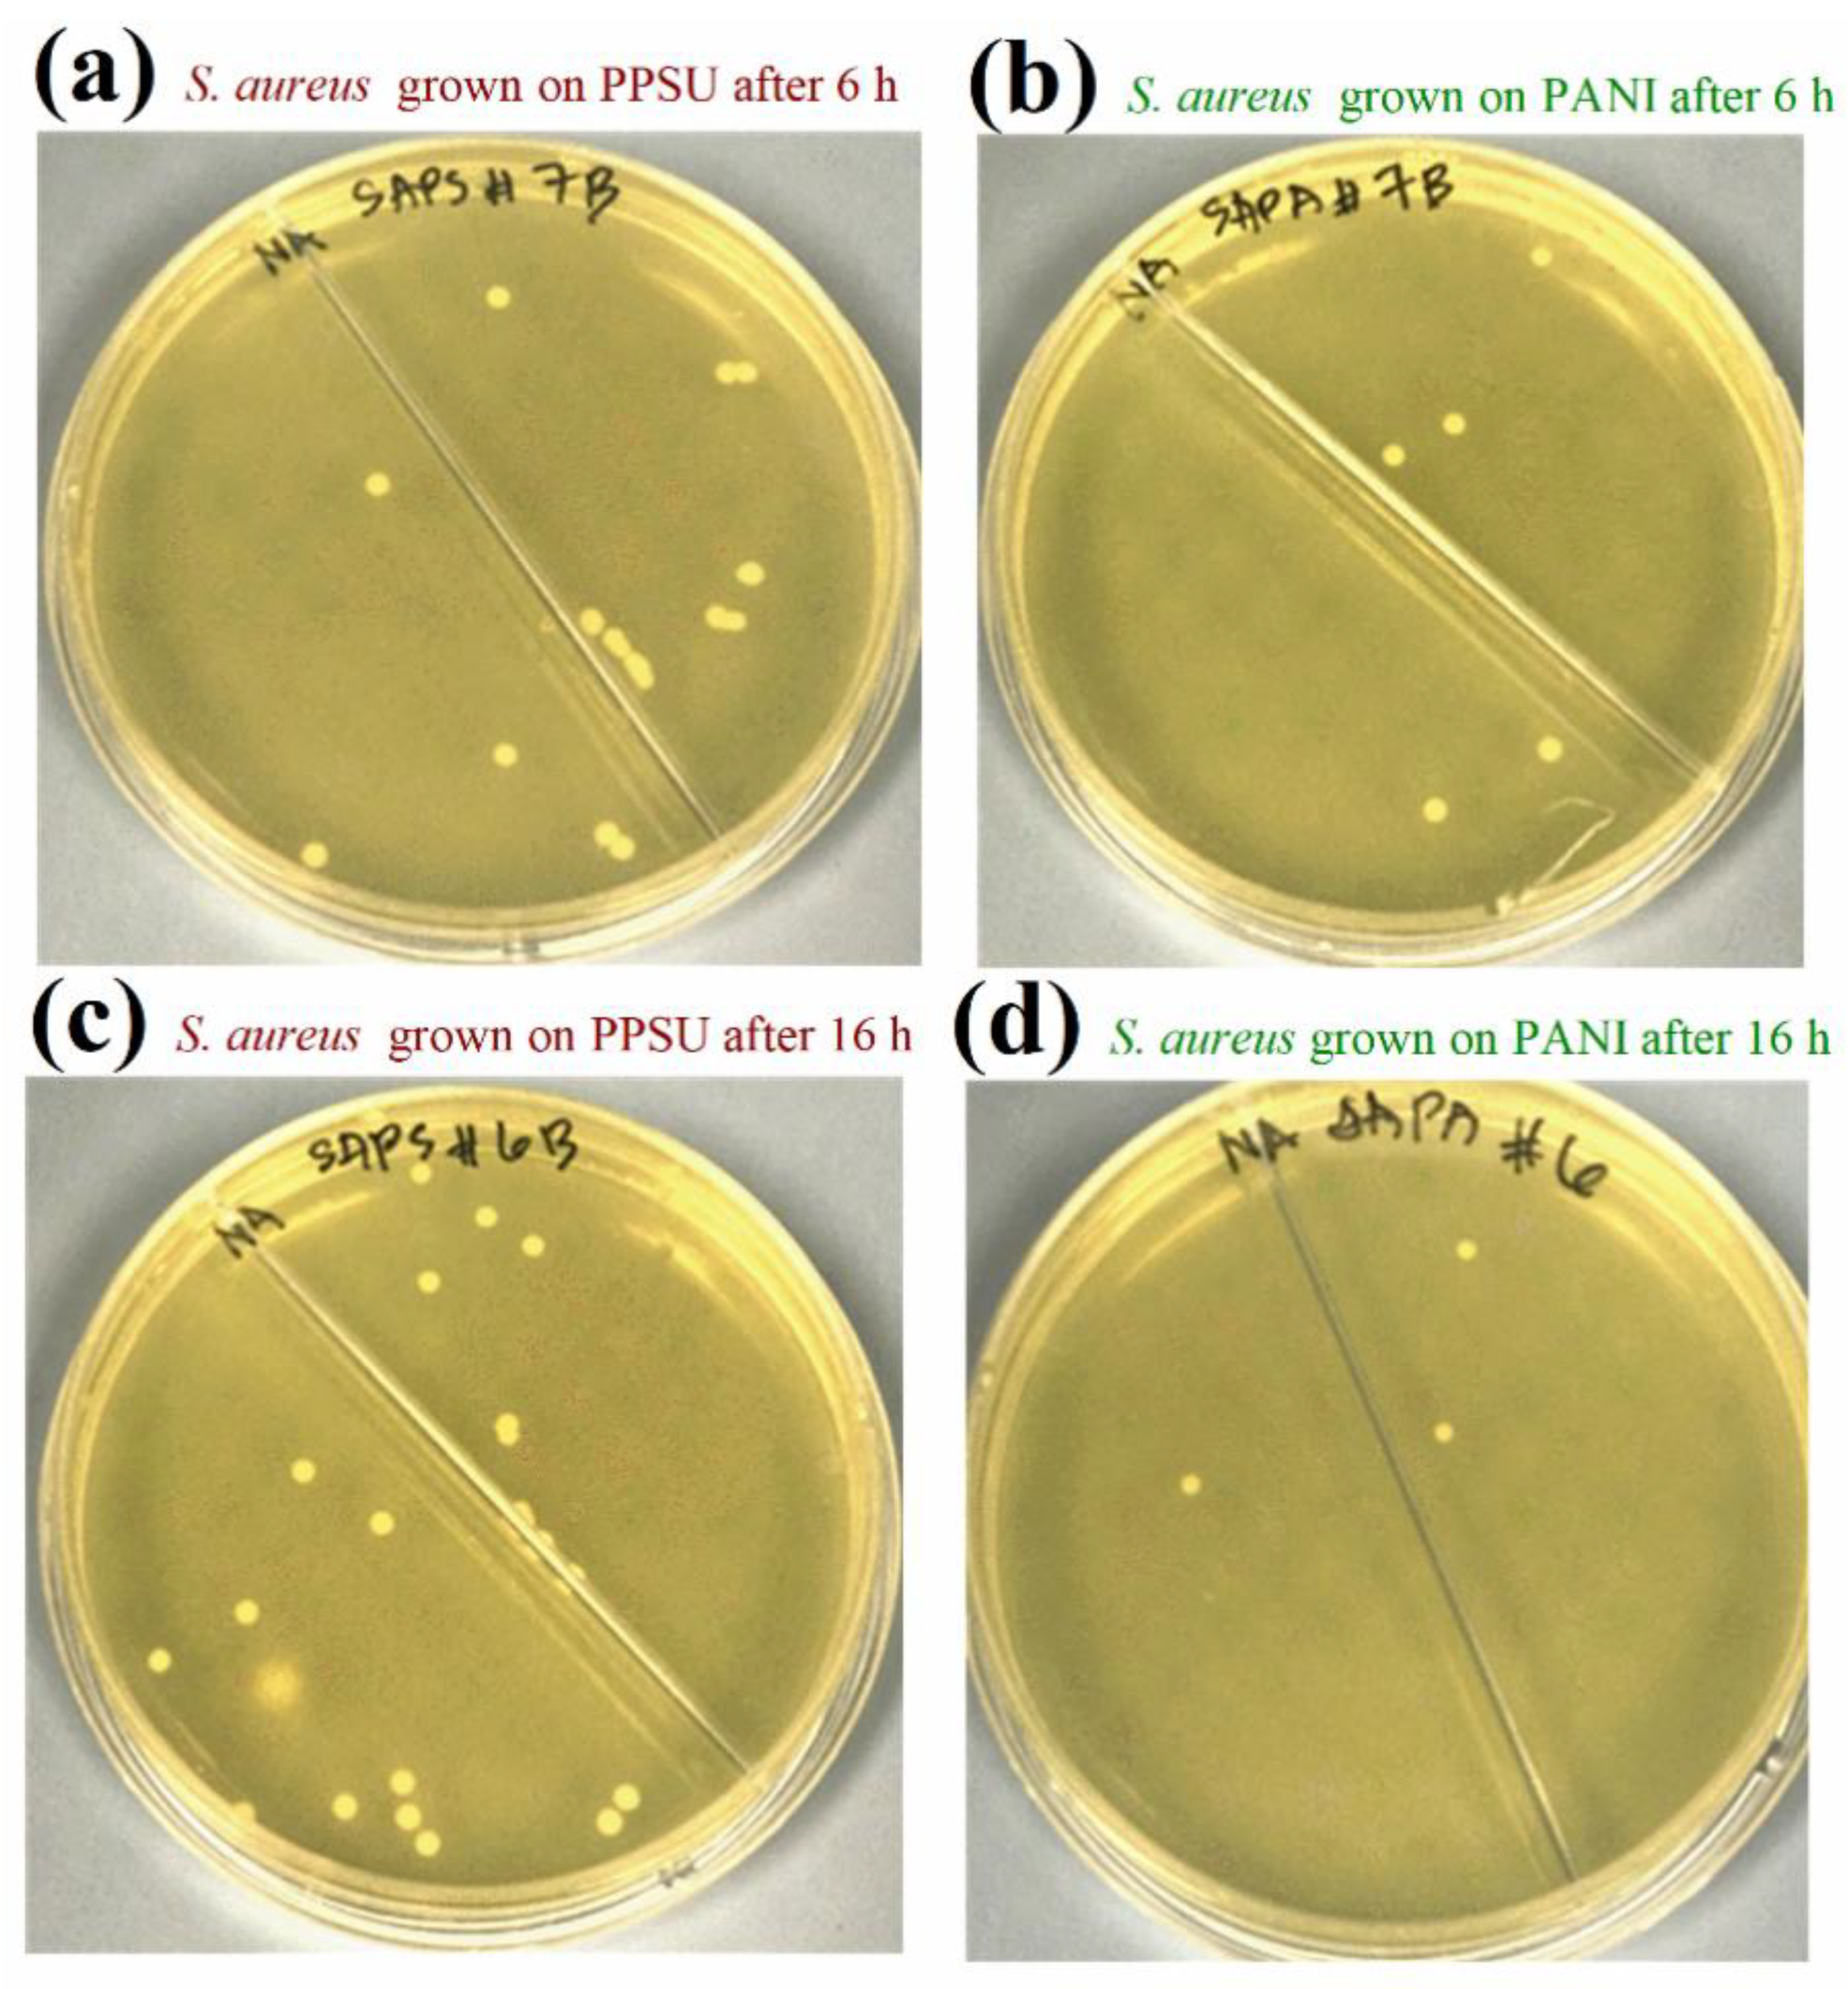
Membranes 11 00025 g010

Dye Separation and Antibacterial Activities of Polyaniline Thin Film-Coated Poly(phenyl sulfone) Membranes
Abstract
1. Introduction
2. Materials and Methods
2.1. Materials
2.2. Fabrication of PPSU Support Membrane
2.3. Deposition of a PANI Thin Film on the PPSU Membrane
2.4. Characterization
2.4.1. Scanning Electron Microscopy (SEM)
2.4.2. Atomic Force Microscopy (AFM)
2.4.3. Contact Angle Measurements
2.4.4. Zeta Potential Measurements
2.5. Membrane Performance Assessment
2.5.1. Experimental Setup and Water Filtration Procedure
2.5.2. Experimental Setup Used to Evaluate MB Dye Rejection
2.6. Antibacterial Activities and Anti-Adhesive Properties of the Membranes
2.6.1. Antibacterial Activity
2.6.2. Effects of PANI on Bacterial Cell Morphology and Adhesion
3. Results and Discussion
3.1. Membrane Morphology
3.2. Membrane Hydrophilicity
3.3. Zeta Potentials of the Membrane Surfaces
3.4. Water Permeability and Rejection of the MB Dye
3.5. Antibacterial Activities of the Membranes
3.6. Effects of PANI Deposition on the Morphology and Adhesion of Model Bacterial Cells
4. Conclusions
Author Contributions
Funding
Institutional Review Board Statement
Informed Consent Statement
Acknowledgments
Conflicts of Interest
References
- Lau, W.J.; Ismail, A.F.; Misdan, N.; Kassim, M.A. A recent progress in thin film composite membrane: A review. Desalination 2012, 287, 190–199. [Google Scholar] [CrossRef]
- Le, N.L.; Nunes, S.P. Materials and membrane technologies for water and energy sustainability. Sustain. Mater. Technol. 2016, 7, 1–28. [Google Scholar] [CrossRef]
- Pandey, N.; Shukla, S.K.; Singh, N.B. Water purification by polymer nanocomposites: An overview. Nanocomposites 2017, 3, 47–66. [Google Scholar] [CrossRef]
- Mokhena, T.C.; Luyt, A.S. Development of multifunctional nano/ultrafiltration membrane based on a chitosan thin film on alginate electrospun nanofibres. J. Clean. Prod. 2017, 156, 470–479. [Google Scholar] [CrossRef]
- Abou Hammad, A.B.; Hemdan, B.A.; El Nahrawy, A.M. Facile synthesis and potential application of Ni0.6Zn0.4Fe2O4 and Ni0.6Zn0.2Ce0.2Fe2O4 magnetic nanocubes as a new strategy in sewage treatment. J. Environ. Manage. 2020, 270, 110816. [Google Scholar] [CrossRef]
- Shukla, A.K.; Alam, J.; Ali, F.A.A.; Alhoshan, M. Efficient soluble anionic dye removal and antimicrobial properties of ZnO embedded-polyphenylsulfone membrane. Water Environ. J. 2020, 0, 1–15. [Google Scholar] [CrossRef]
- Richards, H.L.; Baker, P.G.L.; Iwuoha, E. Metal Nanoparticle Modified Polysulfone Membranes for Use in Wastewater Treatment: A Critical Review. J. Surf. Eng. Mater. Adv. Technol. 2012, 2, 183–193. [Google Scholar] [CrossRef]
- Phelane, L.; Muya, F.N.; Richards, H.L.; Baker, P.G.L.; Iwuoha, E.I. Polysulfone Nanocomposite Membranes with improved hydrophilicity. Electrochim. Acta 2014, 128, 326–335. [Google Scholar] [CrossRef]
- Kang, G.; Cao, Y. Application and modification of poly(vinylidene fluoride) (PVDF) membranes—A review. J. Memb. Sci. 2014, 463, 145–165. [Google Scholar] [CrossRef]
- Shukla, A.K.; Alam, J.; Rahaman, M.; Alrehaili, A.; Alhoshan, M.; Aldalbahi, A. A Facile Approach for Elimination of Electroneutral/Anionic Organic Dyes from Water Using a Developed Carbon-Based Polymer Nanocomposite Membrane. Water. Air. Soil Pollut. 2020, 231. [Google Scholar] [CrossRef]
- Rana, D.; Matsuura, T. Surface modifications for antifouling membranes. Chem. Rev. 2010, 110, 2448–2471. [Google Scholar] [CrossRef] [PubMed]
- Shin, D.H.; Kim, N.; Lee, Y.T. Modification to the polyamide TFC RO membranes for improvement of chlorine-resistance. J. Memb. Sci. 2011, 376, 302–311. [Google Scholar] [CrossRef]
- Dadashi Firouzjaei, M.; Arabi Shamsabadi, A.; Aghapour Aktij, S.; Seyedpour, S.F.; Sharifian Gh., M.; Rahimpour, A.; Rabbani Esfahani, M.; Ulbricht, M.; Soroush, M. Exploiting Synergetic Effects of Graphene Oxide and a Silver-Based Metal−Organic Framework To Enhance Antifouling and Anti- Biofouling Properties of Thin-Film Nanocomposite Membranes. ACS Appl. Mater. Interfaces 2018, 10, 42967–42978. [Google Scholar] [CrossRef] [PubMed]
- Wang, J.; Wang, Y.; Zhang, Y.; Uliana, A.; Zhu, J.; Liu, J.; Van Der Bruggen, B. Zeolitic Imidazolate Framework/Graphene Oxide Hybrid Nanosheets Functionalized Thin Film Nanocomposite Membrane for Enhanced Antimicrobial Performance. ACS Appl. Mater. Interfaces 2016, 8, 25508–25519. [Google Scholar] [CrossRef] [PubMed]
- Liu, G.; Jin, W.; Xu, N. Graphene-based membranes. Chem. Soc. Rev. 2015, 44, 5016–5030. [Google Scholar] [CrossRef]
- Zhu, S.; Shi, M.; Zhao, S.; Wang, Z.; Wang, J.; Wang, S. Preparation and characterization of a polyethersulfone/polyaniline nanocomposite membrane for ultrafiltration and as a substrate for a gas separation membrane. RSC Adv. 2015, 5, 27211–27223. [Google Scholar] [CrossRef]
- Guo, J.; Kim, J. Modifications of polyethersulfone membrane by doping sulfated-TiO2 nanoparticles for improving anti-fouling property in wastewater treatment. RSC Adv. 2017, 7, 33822–33828. [Google Scholar] [CrossRef]
- Fei, F.; Le Phuong, H.A.; Blanford, C.F.; Szekely, G. Tailoring the Performance of Organic Solvent Nanofiltration Membranes with Biophenol Coatings. ACS Appl. Polym. Mater. 2019, 1, 452–460. [Google Scholar] [CrossRef]
- Li, G.; Liu, B.; Bai, L.; Shi, Z.; Tang, X.; Wang, J.; Liang, H.; Zhang, Y.; Van der Bruggen, B. Improving the performance of loose nanofiltration membranes by poly-dopamine/zwitterionic polymer coating with hydroxyl radical activation. Sep. Purif. Technol. 2020, 238, 116412. [Google Scholar] [CrossRef]
- Shukla, A.K.; Alam, J.; Alhoshan, M.; Dass, L.A.; Muthumareeswaran, M.R. Development of a nanocomposite ultrafiltration membrane based on polyphenylsulfone blended with graphene oxide. Sci. Rep. 2017, 7, 41976–41987. [Google Scholar] [CrossRef]
- Wang, Y.; Górecki, R.P.; Stamate, E.; Norrman, K.; Aili, D.; Zuo, M.; Guo, W.; Hélix-Nielsen, C.; Zhang, W. Preparation of super-hydrophilic polyphenylsulfone nanofiber membranes for water treatment. RSC Adv. 2019, 9, 278–286. [Google Scholar] [CrossRef]
- Bhat, S.A.; Zafar, F.; Mondal, A.H.; Mirza, A.U.; Rizwanul Haq, Q.M.; Nishat, N. Efficient removal of Congo red dye from aqueous solution by adsorbent films of polyvinyl alcohol/melamine-formaldehyde composite and bactericidal effects. J. Clean. Prod. 2020, 255, 120062. [Google Scholar] [CrossRef]
- Alam, J.; Dass, L.A.; Alhoshan, M.S.; Mohammad, A.W. Advances in Membrane Development Based on Electrically Conducting Polymers. Adv. Polym. Technol. 2012, 32, E189–E197. [Google Scholar] [CrossRef]
- Additive, S.P.; Mcverry, B.T.; Temple, J.A.T.; Huang, X.; Marsh, K.L.; Hoek, E.M.V.; Kaner, R.B. Fabrication of Low-Fouling Ultra fi ltration Membranes Using a Hydrophilic, Self-Doping Polyaniline Additive. Chem. Mater. 2013, 25, 3597–3602. [Google Scholar]
- Guillen, G.R.; Farrell, T.P.; Kaner, R.B.; Hoek, E.M.V. Pore-structure, hydrophilicity, and particle filtration characteristics of polyaniline–polysulfone ultrafiltration membranes. J. Mater. Chem. 2010, 20, 4621. [Google Scholar] [CrossRef]
- Sairam, M.; Nataraj, S.K.; Aminabhavi, T.M.; Roy, S.; Madhusoodana, C.D. Polyaniline membranes for separation and purification of gases, liquids, and electrolyte solutions. Sep. Purif. Rev. 2006, 35, 249–283. [Google Scholar] [CrossRef]
- Zhao, S.; Wang, Z.; Wei, X.; Zhao, B.; Wang, J.; Yang, S.; Wang, S. Performance improvement of polysulfone ultrafiltration membrane using PANiEB as both pore forming agent and hydrophilic modifier. J. Memb. Sci. 2011, 385–386, 251–262. [Google Scholar] [CrossRef]
- Zhou, X.; Zhang, Z.; Men, X.; Yang, J.; Xu, X.; Zhu, X.; Xue, Q. Fabrication of superhydrophobic polyaniline films with rapidly switchable wettability. Appl. Surf. Sci. 2011, 258, 285–289. [Google Scholar] [CrossRef]
- Bhadra, S.; Khastgir, D.; Singha, N.K.; Lee, J.H. Progress in preparation, processing and applications of polyaniline. Prog. Polym. Sci. 2009, 34, 783–810. [Google Scholar] [CrossRef]
- Leng, W.; Zhou, S.; Gu, G.; Wu, L. Wettability switching of SDS-doped polyaniline from hydrophobic to hydrophilic induced by alkaline/reduction reactions. J. Colloid Interface Sci. 2012, 369, 411–418. [Google Scholar] [CrossRef]
- Fan, Z.; Wang, Z.; Duan, M.; Wang, J.; Wang, S. Preparation and characterization of polyaniline/polysulfone nanocomposite ultrafiltration membrane. J. Memb. Sci. 2008, 310, 402–408. [Google Scholar] [CrossRef]
- Rong, G.; Zhou, D.; Pang, J. Preparation of high-performance antifouling polyphenylsulfone ultrafiltration membrane by the addition of sulfonated polyaniline. J. Polym. Res. 2018, 25, 66. [Google Scholar] [CrossRef]
- Batrinescu, G.; Constantin, M.A.; Cuciureanu, A.; Nechifor, G. Polysulfone–Polyaniline-Type Membranes Obtained in aSteady-State System: Structural and HydrodynamicCharacteristics. Polym. Eng. Sci. 2014, 54, 1640–1647. [Google Scholar] [CrossRef]
- Huang, S.-C.; Ball, I.J.; Kaner, R.B. Polyaniline membranes for pervaporation of carboxylic acids and water. Macromolecules 1998, 31, 5456–5464. [Google Scholar] [CrossRef]
- Yue, J.; Epstein, A.J. XPS study of self-doped conducting polyaniline and parent systems. Macromolecules 1991, 24, 4441–4445. [Google Scholar] [CrossRef]
- Epstein, A.J.; Ginder, J.M.; Zuo, F.; Bigelow, R.W.; Woo, H.-S.; Tanner, D.B.; Richter, A.F.; Huang, W.-S.; MacDiarmid, A.G. Insulator-to-metal transition in polyaniline. Synth. Met. 1987, 18, 303–309. [Google Scholar] [CrossRef]
- Luo, Y.; Guo, R.; Li, T.; Li, F.; Liu, Z.; Zheng, M.; Wang, B.; Yang, Z.; Luo, H.; Wan, Y. Application of Polyaniline for Li-Ion Batteries, Lithium–Sulfur Batteries, and Supercapacitors. ChemSusChem 2019, 12, 1591–1611. [Google Scholar] [CrossRef]
- Zheng, W.; Angelopoulos, M.; Epstein, A.J.; MacDiarmid, A.G. Experimental evidence for hydrogen bonding in polyaniline: Mechanism of aggregate formation and dependency on oxidation state. Macromolecules 1997, 30, 2953–2955. [Google Scholar] [CrossRef]
- Zhang, Y.; Duan, Y.; Liu, J. The Effect of Intermolecular Hydrogen Bonding on the Polyaniline Water Complex. J. Clust. Sci. 2017, 28, 1071–1081. [Google Scholar] [CrossRef]
- Nahrawy, A.M.E.; Bakr, A.M.; Hammad, A.B.A.; Hemdan, B.A. High performance of talented copper/magneso-zinc titanate nanostructures as biocidal agents for inactivation of pathogens during wastewater disinfection. Appl. Nanosci. 2020, 10, 3585–3601. [Google Scholar] [CrossRef]
- Jiang, M.; Ye, K.; Lin, J.; Zhang, X.; Ye, W.; Zhao, S.; Van der Bruggen, B. Effective dye purification using tight ceramic ultrafiltration membrane. J. Memb. Sci. 2018, 566, 151–160. [Google Scholar] [CrossRef]
- Jin, P.; Yuan, S.; Zhang, G.; Zhu, J.; Zheng, J.; Luis, P.; Van der Bruggen, B. Polyarylene thioether sulfone/sulfonated sulfone nanofiltration membrane with enhancement of rejection and permeability via molecular design☆. J. Memb. Sci. 2020, 608, 118241. [Google Scholar] [CrossRef]
- Abdulhamid, M.A.; Park, S.-H.; Vovusha, H.; Akhtar, F.H.; Ng, K.C.; Schwingenschlögl, U.; Szekely, G. Molecular engineering of high-performance nanofiltration membranes from intrinsically microporous poly(ether-ether-ketone). J. Mater. Chem. A 2020, 8, 24445–24454. [Google Scholar] [CrossRef]
- Boomi, P.; Prabu, H.G.; Manisankar, P.; Ravikumar, S. Study on antibacterial activity of chemically synthesized PANI-Ag-Au nanocomposite. Appl. Surf. Sci. 2014, 300, 66–72. [Google Scholar] [CrossRef]
- Tamboli, M.S.; Kulkarni, M.V.; Patil, R.H.; Gade, W.N.; Navale, S.C.; Kale, B.B. Nanowires of silver-polyaniline nanocomposite synthesized via in situ polymerization and its novel functionality as an antibacterial agent. Colloids Surfaces B Biointerfaces 2012, 92, 35–41. [Google Scholar] [CrossRef]
- Ghaffari-Moghaddam, M.; Eslahi, H. Synthesis, characterization and antibacterial properties of a novel nanocomposite based on polyaniline/polyvinyl alcohol/Ag. Arab. J. Chem. 2014, 7, 846–855. [Google Scholar] [CrossRef]
- Boomi, P.; Prabu, H.G.; Mathiyarasu, J. Synthesis, characterization and antibacterial activity of polyaniline/Pt-Pd nanocomposite. Eur. J. Med. Chem. 2014, 72, 18–25. [Google Scholar] [CrossRef]
- Boomi, P.; Prabu, H.G.; Mathiyarasu, J. Synthesis and characterization of polyaniline/Ag-Pt nanocomposite for improved antibacterial activity. Colloids Surfaces B Biointerfaces 2013, 103, 9–14. [Google Scholar] [CrossRef]
- Kooti, M.; Kharazi, P.; Motamedi, H. Preparation, characterization, and antibacterial activity of CoFe2O4/polyaniline/Ag nanocomposite. J. Taiwan Inst. Chem. Eng. 2014, 45, 2698–2704. [Google Scholar] [CrossRef]
- Bogdanović, U.; Vodnik, V.; Mitrić, M.; Dimitrijević, S.; Škapin, S.D.; Žunič, V.; Budimir, M.; Stoiljković, M. Nanomaterial with High Antimicrobial Efficacy—Copper/Polyaniline Nanocomposite. ACS Appl. Mater. Interfaces 2015, 7, 1955–1966. [Google Scholar] [CrossRef]
- Wu, C. Preparation and characterization of an aromatic polyester/polyaniline composite and its improved counterpart. Express Polym. Lett. 2012, 6, 26–40. [Google Scholar] [CrossRef]
- Razali, N.F.; Mohammad, A.W.; Hilal, N. Effects of polyaniline nanoparticles in polyethersulfone ultrafiltration membranes: Fouling behaviours by different types of foulant. J. Ind. Eng. Chem. 2014, 20, 3134–3140. [Google Scholar] [CrossRef]
- Dhivya, C.; Vandarkuzhali, S.A.A.; Radha, N. Antimicrobial activities of nanostructured polyanilines doped with aromatic nitro compounds. Arab. J. Chem. 2019, 12, 3785–3798. [Google Scholar] [CrossRef]
- Prabhakar, P.K.; Raj, S.; Anuradha, P.R.; Sawant, S.N.; Doble, M. Biocompatibility studies on polyaniline and polyaniline–silver nanoparticle coated polyurethane composite. Colloids Surfaces B Biointerfaces 2011, 86, 146–153. [Google Scholar] [CrossRef]
- Liang, X.; Sun, M.; Li, L.; Qiao, R.; Chen, K.; Xiao, Q.; Xu, F. Preparation and antibacterial activities of polyaniline/Cu0.05Zn0.95O nanocomposites. Dalt. Trans. 2012, 41, 2804–2811. [Google Scholar] [CrossRef]
- Wu, C.-S. Aliphatic–aromatic polyester–polyaniline composites: Preparation, characterization, antibacterial activity and conducting properties. Polym. Int. 2012, 61, 1556–1563. [Google Scholar] [CrossRef]
- Gizdavic-Nikolaidis, M.R.; Bennett, J.R.; Swift, S.; Easteal, A.J.; Ambrose, M. Broad spectrum antimicrobial activity of functionalized polyanilines. Acta Biomater. 2011, 7, 4204–4209. [Google Scholar] [CrossRef]

| Membranes | Isoelectric Point (pHiep) | Water Permeability (L·m−2·h−1·bar−1) | Dye Rejection (%) |
|---|---|---|---|
| PPSU membrane | 3.4 | 20.3 ± 3 | 3 ± 0.5 |
| PANI-coated PPSU membrane | 5.2 | 53.5 ± 5 | 96 ± 2 |
Publisher’s Note: MDPI stays neutral with regard to jurisdictional claims in published maps and institutional affiliations. |
© 2020 by the authors. Licensee MDPI, Basel, Switzerland. This article is an open access article distributed under the terms and conditions of the Creative Commons Attribution (CC BY) license (http://creativecommons.org/licenses/by/4.0/).
Share and Cite
Alam, J.; Shukla, A.K.; Ansari, M.A.; Ali, F.A.A.; Alhoshan, M. Dye Separation and Antibacterial Activities of Polyaniline Thin Film-Coated Poly(phenyl sulfone) Membranes. Membranes 2021, 11, 25. https://doi.org/10.3390/membranes11010025
Alam J, Shukla AK, Ansari MA, Ali FAA, Alhoshan M. Dye Separation and Antibacterial Activities of Polyaniline Thin Film-Coated Poly(phenyl sulfone) Membranes. Membranes. 2021; 11(1):25. https://doi.org/10.3390/membranes11010025
Chicago/Turabian StyleAlam, Javed, Arun Kumar Shukla, Mohammad Azam Ansari, Fekri Abdulraqeb Ahmed Ali, and Mansour Alhoshan. 2021. "Dye Separation and Antibacterial Activities of Polyaniline Thin Film-Coated Poly(phenyl sulfone) Membranes" Membranes 11, no. 1: 25. https://doi.org/10.3390/membranes11010025
APA StyleAlam, J., Shukla, A. K., Ansari, M. A., Ali, F. A. A., & Alhoshan, M. (2021). Dye Separation and Antibacterial Activities of Polyaniline Thin Film-Coated Poly(phenyl sulfone) Membranes. Membranes, 11(1), 25. https://doi.org/10.3390/membranes11010025

